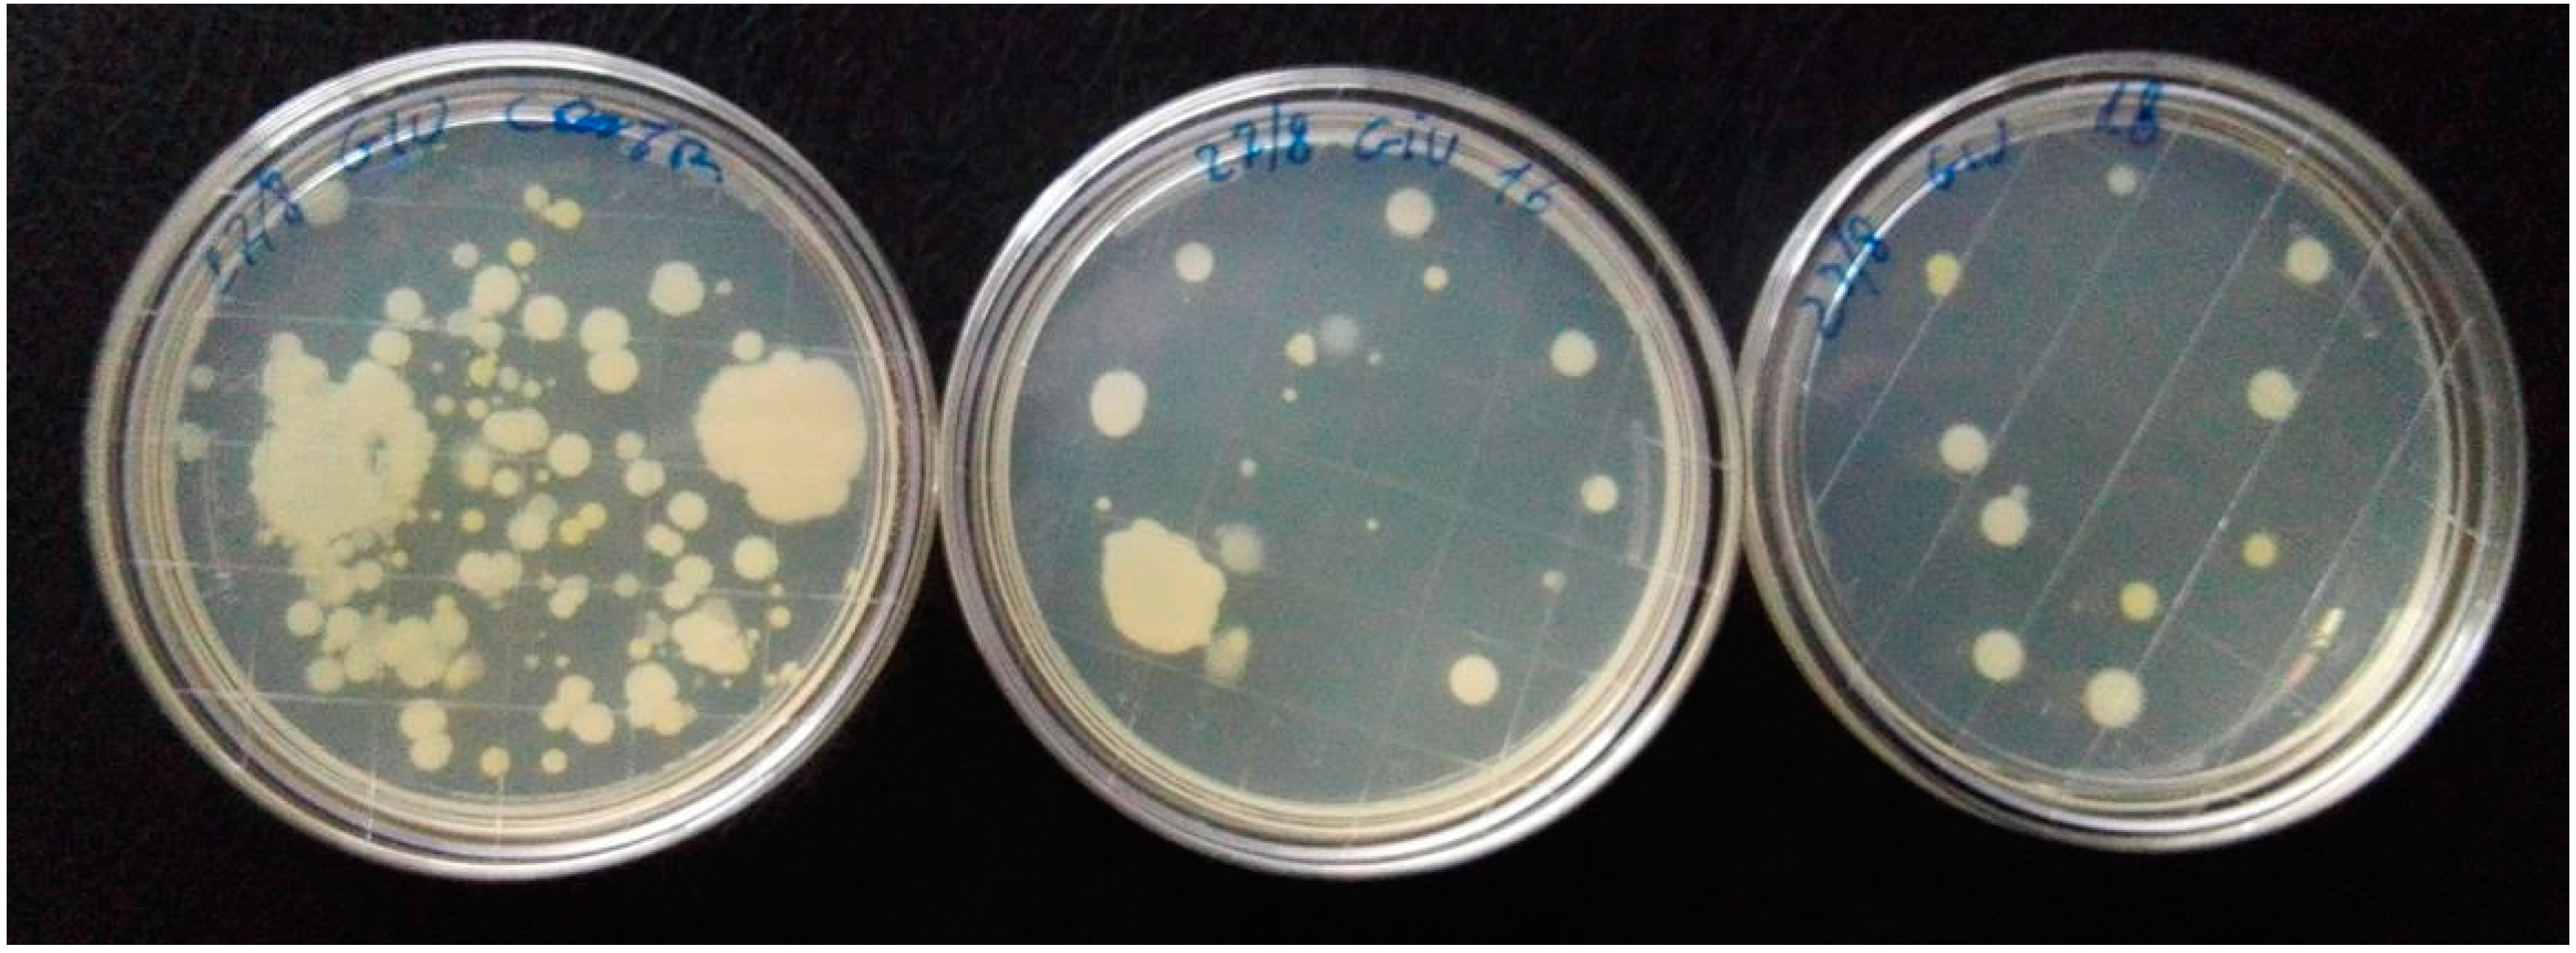
Ijerph 13 00940 g002 550

Time Effectiveness of Ultraviolet C Light (UVC) Emitted by Light Emitting Diodes (LEDs) in Reducing Stethoscope Contamination
Abstract
:1. Introduction
2. Materials and Methods
2.1. Setting
2.2. Experimental Protocol
2.3. Statistical Analysis
3. Results
4. Discussion
5. Conclusions
Acknowledgments
Author Contributions
Conflicts of Interest
References
- World Health Organization. Report on the Burden of Endemic Health Care-Associated Infection Worldwide; WHO Document Production Services: Geneva, Switzerland, 2011; pp. 1–34. [Google Scholar]
- Zimlichman, E.; Henderson, D.; Tamir, O.; Franz, C.; Song, P.; Yamin, C.K.; Keohane, C.; Denham, C.R.; Bates, D.W. Health care-associated infections: A meta-analysis of costs and financial impact on the US health care system. JAMA Intern. Med. 2013, 173, 2039–2046. [Google Scholar] [CrossRef] [PubMed]
- O’Flaherty, N.; Fenelon, L. The stethoscope and healthcare-associated infection: A snake in the grass or innocent bystander? J. Hosp. Infect. 2015, 91, 1–7. [Google Scholar] [CrossRef] [PubMed]
- Otter, J.A.; Yezli, S.; French, G.L. The role played by contaminated surfaces in the transmission of nosocomial pathogens. Infect. Control Hosp. Epidemiol. 2011, 32, 687–699. [Google Scholar] [CrossRef] [PubMed]
- Weber, D.J.; Rutala, W.A.; Miller, M.B.; Huslage, K.; Sickbert-Bennett, E. Role of hospital surfaces in the transmission of emerging health care-associated pathogens: Norovirus, Clostridium difficile, and Acinetobacter species. Am. J. Infect. Control 2010, 38, S25–S33. [Google Scholar] [CrossRef] [PubMed]
- Africa-Purino, F.; Edwin, E.; Coronel, R. Stethoscopes: A potential source of nosocomial infections. Available online: http://www.psmid.org.ph/vol29/vol29num1topic2.pdf (accessed on 19 February 2016 ).
- Zachary, K.C.; Bayne, P.S.; Morrison, V.J.; Ford, D.S.; Silver, L.C.; Hooper, D.C. Contamination of gowns, gloves, and stethoscopes with vancomycin-resistant enterococci. Infect. Control Hosp. Epidemiol. 2001, 22, 560–564. [Google Scholar] [CrossRef] [PubMed]
- Kramer, A.; Schwebke, I.; Kampf, G. How long do nosocomial pathogens persist on inanimate surfaces? A systematic review. BMC Infect. Dis. 2006, 6, 130. [Google Scholar] [CrossRef] [PubMed]
- Longtin, Y.; Schneider, A.; Tschopp, C.; Renzi, G.; Gayet-Ageron, A.; Schrenzel, J.; Pittet, D. Contamination of stethoscopes and physicians’ hands after a physical examination. Mayo Clin. Proc. 2014, 89, 291–299. [Google Scholar] [CrossRef] [PubMed]
- Crespo, M.P.; Woodford, N.; Sinclair, A.; Kaufmann, M.E.; Turton, J.; Glover, J.; Velez, J.D.; Castaneda, C.R.; Recalde, M.; Livermore, D.M. Outbreak of carbapenem-resistant Pseudomonas aeruginosa producing VIM-8, a novel metallo-beta-lactamase, in a tertiary care center in Cali, Colombia. J. Clin. Microbiol. 2004, 42, 5094–5101. [Google Scholar] [CrossRef] [PubMed]
- Gastmeier, P.; Groneberg, K.; Weist, K.; Ruden, H. A cluster of nosocomial Klebsiella pneumoniae bloodstream infections in a neonatal intensive care department: Identification of transmission and intervention. Am. J. Infect. Control 2003, 31, 424–430. [Google Scholar] [CrossRef] [PubMed]
- Grecia, S.C.; Malanyaon, O.; Aguirre, C. The effect of an educational intervention on the contamination rates of stethoscopes and on the knowledge, attitudes, and practices regarding the stethoscope use of healthcare providers in a tertiary care hospital. Philipp. J. Microbiol. Infect. Dis. 2008, 37, 20–33. [Google Scholar]
- Messina, G.; Burgassi, S.; Messina, D.; Montagnani, V.; Cevenini, G. A new UV-LED device for automatic disinfection of stethoscope membranes. Am. J. Infect. Control 2015, 43, e61–e66. [Google Scholar] [CrossRef] [PubMed]
- Kowalski, W. Ultraviolet Germicidal Irradiation Handbook: Uvgi for Air Surface Disinfection; Springer: Berlin, Germany, 2009. [Google Scholar]
- Weist, K.; Pollege, K.; Schulz, I.; Ruden, H.; Gastmeier, P. How many nosocomial infections are associated with cross-transmission? A prospective cohort study in a surgical intensive care unit. Infect. Control Hosp. Epidemiol. 2002, 23, 127–132. [Google Scholar] [CrossRef] [PubMed]
- Cohen, H.A.; Amir, J.; Matalon, A.; Mayan, R.; Beni, S.; Barzilai, A. Stethoscopes and otoscopes--A potential vector of infection? Fam. Pract. 1997, 14, 446–449. [Google Scholar] [CrossRef] [PubMed]
- Zuniga, A.; Manalich, J.; Cortes, R. Stethoscope or staphyloscope?: Potential vector in nosocomial infections. Rev. Chilena Infectol. 2016, 33, 19–25. [Google Scholar] [PubMed]
- Rutala, W.A.; Weber, D.J. Disinfectants used for environmental disinfection and new room decontamination technology. Am. J. Infect. Control 2013, 41, S36–S41. [Google Scholar] [CrossRef] [PubMed]
- Russell, A.D. Bacterial adaptation and resistance to antiseptics, disinfectants and preservatives is not a new phenomenon. J. Hosp. Infect. 2004, 57, 97–104. [Google Scholar] [CrossRef] [PubMed]
- Maillard, J.Y.; Bloomfield, S.; Coelho, J.R.; Collier, P.; Cookson, B.; Fanning, S.; Hill, A.; Hartemann, P.; McBain, A.J.; Oggioni, M.; et al. Does microbicide use in consumer products promote antimicrobial resistance? A critical review and recommendations for a cohesive approach to risk assessment. Microb. Drug Resist. 2013, 19, 344–354. [Google Scholar] [PubMed]
- Russell, A.D. Bacterial resistance to disinfectants: Present knowledge and future problems. J. Hosp. Infect. 1999, 43, S57–S68. [Google Scholar] [CrossRef]
- Nerandzic, M.M.; Cadnum, J.L.; Eckart, K.E.; Donskey, C.J. Evaluation of a hand-held far-ultraviolet radiation device for decontamination of Clostridium difficile and other healthcare-associated pathogens. BMC Infect. Dis. 2012, 12, 120. [Google Scholar] [CrossRef] [PubMed]
- Anderson, D.J.; Gergen, M.F.; Smathers, E.; Sexton, D.J.; Chen, L.F.; Weber, D.J.; Rutala, W.A. Decontamination of targeted pathogens from patient rooms using an automated ultraviolet-c-emitting device. Infect. Control Hosp. Epidemiol. 2013, 34, 466–471. [Google Scholar] [CrossRef] [PubMed]
- Boyce, J.M.; Havill, N.L.; Moore, B.A. Terminal decontamination of patient rooms using an automated mobile uv light unit. Infect. Control Hosp. Epidemiol. 2011, 32, 737–742. [Google Scholar] [CrossRef] [PubMed]
- Graves, N.; McGowan, J.E., Jr. Nosocomial infection, the deficit reduction act, and incentives for hospitals. JAMA 2008, 300, 1577–1579. [Google Scholar] [CrossRef] [PubMed]
- Douglas Scott, R., II. The Direct Medical Costs of Healthcare-Associated Infections in U.S. Hospitals and the Benefits of Prevention; Division of Healthcare Quality Promotion National Center for Preparedness, Detection and Control of Infectious Diseases Coordinating Center for Infectious Diseases; Centers for Disease Control and Prevention: Atlanta, GA, USA, 2009.
- Saloojee, H.; Steenhoff, A. The health professional’s role in preventing nosocomial infections. Postgrad. Med. J. 2001, 77, 16–19. [Google Scholar] [CrossRef] [PubMed]
- Maki, D.G. Stethoscopes and health care-associated infection. Mayo Clin. Proc. 2014, 89, 277–280. [Google Scholar] [CrossRef] [PubMed]
- Fattorini, M.; Ceriale, E.; Nante, N.; Lenzi, D.; Manzi, P.; Basagni, C.; Messina, G. Use of a fluorescent marker for assessing hospital bathroom cleanliness. Am. J. Infect. Control 2016, 44, 1066–1068. [Google Scholar] [CrossRef] [PubMed]

© 2016 by the authors; licensee MDPI, Basel, Switzerland. This article is an open access article distributed under the terms and conditions of the Creative Commons Attribution (CC-BY) license (http://creativecommons.org/licenses/by/4.0/).
Share and Cite
Messina, G.; Fattorini, M.; Nante, N.; Rosadini, D.; Serafini, A.; Tani, M.; Cevenini, G. Time Effectiveness of Ultraviolet C Light (UVC) Emitted by Light Emitting Diodes (LEDs) in Reducing Stethoscope Contamination. Int. J. Environ. Res. Public Health 2016, 13, 940. https://doi.org/10.3390/ijerph13100940
Messina G, Fattorini M, Nante N, Rosadini D, Serafini A, Tani M, Cevenini G. Time Effectiveness of Ultraviolet C Light (UVC) Emitted by Light Emitting Diodes (LEDs) in Reducing Stethoscope Contamination. International Journal of Environmental Research and Public Health. 2016; 13(10):940. https://doi.org/10.3390/ijerph13100940
Chicago/Turabian StyleMessina, Gabriele, Mattia Fattorini, Nicola Nante, Daniele Rosadini, Andrea Serafini, Marco Tani, and Gabriele Cevenini. 2016. "Time Effectiveness of Ultraviolet C Light (UVC) Emitted by Light Emitting Diodes (LEDs) in Reducing Stethoscope Contamination" International Journal of Environmental Research and Public Health 13, no. 10: 940. https://doi.org/10.3390/ijerph13100940
APA StyleMessina, G., Fattorini, M., Nante, N., Rosadini, D., Serafini, A., Tani, M., & Cevenini, G. (2016). Time Effectiveness of Ultraviolet C Light (UVC) Emitted by Light Emitting Diodes (LEDs) in Reducing Stethoscope Contamination. International Journal of Environmental Research and Public Health, 13(10), 940. https://doi.org/10.3390/ijerph13100940
